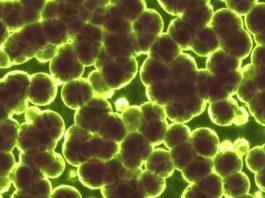

Ученые создали уникальную микроткань для доставки медикаментов в мозг
Сегодня талантливая команда специалистов по медицинскому инжинирингу из Массачусетского Технологического Института пред...
Обнаружен ген, улучшающий адаптивность бактерий
Бактерии являются нашими самыми главными противниками – потому как они постоянно развиваются и развивают в себе высокую...
Найден эмбрион двухголовой акулы
Исследователи из Испании обнаружили чрезвычайно редкий двухголовый зародыш акулы. До этого момента, двухголовые акулята ...
Изобретена уникальная нано-технология для аккумуляторов
Исследователи из Калифорнийского Университета изобрели уникальный тип материала для стандартных батарей, который характе...
Ученые восстанавливают мышечную ткань крысы и планируют перейти на людей
Мышца, потерянная в результате травматического повреждения или врожденного дефекта, или даже удаления опухоли, может ско...
Оптическое устройство наподобие носа собаки «пронюхает» любую болезнь
Когда те или иные процессы в нашем организме выходят за пределы нормы ввиду болезни или инфекции, например, набор молеку...
FDA ускоряет распространение лекарства против миеломы
Сегодня Федеральная Комиссия по контролю качества продуктов питания и медикаментов США постановила как можно быстрее ус...
Купальники для морских черепах помогают их изучить
Если задаетесь вопросом, что лучшее из своего гардероба морские черепахи могут надеть на пляж в этот сезон, то у универс...
Доказано, что вейпы не на много безопасней обычных сигарет
Несколько лет назад на рынке появился совершенно новый продукт, который сразу же стал невероятно популярным по всему мир...
Ученые нашли новый-старый орган у человека
Не так давно казалось, что все органы, которыми мы обладаем, известны и изучению подлежат только проходящие там процессы...